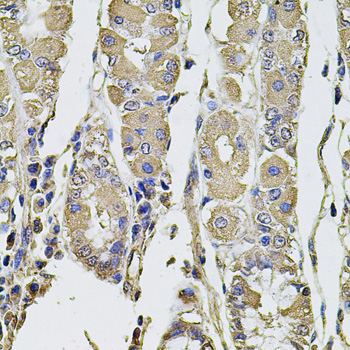
Immunohistochemistry - PTHLH Polyclonal Antibody

-
Product Name
PTHLH Polyclonal Antibody
- Documents
-
Description
Polyclonal antibody to PTHLH
-
Tested applications
WB, IHC
-
Species reactivity
Human
-
Alternative names
PTHLH antibody; BDE2 antibody; HHM antibody; PLP antibody; PTHR antibody; PTHRP antibody; parathyroid hormone like hormone antibody
-
Isotype
Rabbit IgG
-
Preparation
Antigen: Recombinant fusion protein containing a sequence corresponding to amino acids 74-130 of human PTHLH (NP_945316.1).
-
Clonality
Polyclonal
-
Formulation
PBS with 0.02% sodium azide, 50% glycerol, pH7.3.
-
Storage instructions
Store at -20℃. Avoid freeze / thaw cycles.
-
Applications
WB 1:500 - 1:2000
IHC 1:50 - 1:200 -
Validations

Immunohistochemistry - PTHLH Polyclonal Antibody
Immunohistochemistry of paraffin-embedded human prostate using PTHLH antibody at dilution of 1:100 (40x lens).
Immunohistochemistry - PTHLH Polyclonal Antibody
Immunohistochemistry of paraffin-embedded human stomach using PTHLH antibody at dilution of 1:100 (40x lens).
-
Background
Neuroendocrine peptide which is a critical regulator of cellular and organ growth, development, migration, differentiation and survival and of epithelial calcium ion transport. Regulates endochondral bone development and epithelial-mesenchymal interactions during the formation of the mammary glands and teeth. Required for skeletal homeostasis. Promotes mammary mesenchyme differentiation and bud outgrowth by modulating mesenchymal cell responsiveness to BMPs. Upregulates BMPR1A expression in the mammary mesenchyme and this increases the sensitivity of these cells to BMPs and allows them to respond to BMP4 in a paracrine and/or autocrine fashion. BMP4 signaling in the mesenchyme, in turn, triggers epithelial outgrowth and augments MSX2 expression, which causes the mammary mesenchyme to inhibit hair follicle formation within the nipple sheath (By similarity). Promotes colon cancer cell migration and invasion in an integrin alpha-6/beta-1-dependent manner through activation of Rac1.; Osteostatin is a potent inhibitor of osteoclastic bone resorption.
Related Products / Services
Please note: All products are "FOR RESEARCH USE ONLY AND ARE NOT INTENDED FOR DIAGNOSTIC OR THERAPEUTIC USE"
